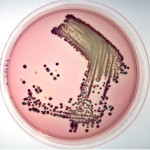
HAL006

Harlequin Chromogenic Media雙色培養基-Lab M

| 代理廠牌: |  |
| 原廠連結: | |
| 相關下載: |
特點
- 雙色判讀,簡易快速。
- 符合食品安全及臨床診斷規範(ISO 9001:2000 / SO13485/醫材歐盟CE驗證IVD)。
| 商品編號 | 商品名稱 | 圖示 |
| HAL008 | Harlequin E.coli / Coliform Medium |  |
| HAL010 | Harlequin Listeria Chromogenic Agar |  |
| HAL001 | Harlequin Salmonella ABC Medium |  |
| HAL006 | Harlequin SMAC-BCIG | |